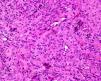
fig0015

Adolescente de 14 años de edad sin antecedentes personales de interés que consultó por una lesión en la encía superior de mes y medio de evolución. Refería un aumento progresivo de tamaño, molestias y sangrado leve con el roce.
Exploración físicaA la exploración física presentaba una lesión polipoide de 5mm de color mucosa normal y consistencia elástica firme, localizada entre los incisivos medial y lateral de la encía superior derecha (fig. 1). No se observaron alteraciones o desplazamientos dentarios, ni otras lesiones en la cavidad oral o la región cervical. Se realizó curetaje de la lesión y hemostasia con nitrato de plata.
HistopatologíaEl estudio histológico mostraba tejido fibroso con prominentes fibroblastos fusiformes, entre los que se identificaban trabéculas de hueso lamelar (figs. 2 y 3). Las técnicas inmunohistoquímicas demostraban positividad de la población celular con vimentina y positividad media del 23% con KI-67, resultando negativos los marcadores CD 31, CD 34, factor de von Willebrand, citoqueratina AE1/AE3, antígeno epitelial de membrana, actina de músculo liso, actina muscular específica, desmina, CD 68 y proteína S 100.
¿Cuál es su diagnóstico?
DiagnósticoFibroma cemento-osificante periférico (FCOP).
Evolución y tratamientoDos semanas después la encía mostraba buen aspecto, sin apreciarse recidiva ni lesión residual.
ComentarioEl FCOP es una hiperplasia reactiva fibroósea osteogénica. Se postula su probable origen en las células multipotenciales del ligamento periodontal por su localización casi exclusiva en las encías, la relación inversa entre la edad e incidencia y la presencia de fibras de oxitalán en la matriz calcificada de algunos FCOP. La etiopatogenia es desconocida; se ha relacionado con traumatismos, presencia de restos ectópicos del ligamento periodontal, influencia de hormonas sexuales femeninas o factores irritantes crónicos, como cálculo dental, biopelícula, prótesis dentales mal ajustadas, malposición dentaria o restauraciones dentarias irregulares1. La irritación crónica del periostio y el periodonto formaría tejido de granulación reactivo que acabaría fibrosándose y calcificándose2.
El FCOP es infrecuente, con mayor incidencia en mujeres de raza blanca en la segunda o tercera décadas de la vida, y supone el 3,1% de las tumoraciones orales biopsiadas1,2.
Se presenta como una lesión asintomática de crecimiento lento en la mayoría de los casos, aunque se han descrito FCOP de gran tamaño con desplazamiento de dientes adyacentes o asimetría facial1. A la exploración física se presenta como una tumoración sésil o pediculada, eritematosa o del color de la mucosa normal, firme, menor de 2cm de diámetro, localizada en la papila interdental1. En la mayoría de los casos aparece en el hueso maxilar anterior3.
El diagnóstico se basa en la correlación clínico-radiológica-anatomopatológica4. Histológicamente es una lesión no encapsulada, revestida por epitelio estratificado escamoso no queratinizante intacto o ulcerado, compuesta por tejido conjuntivo, abundantes fibroblastos de gran tamaño y células inflamatorias crónicas. En profundidad presenta material mineralizado tipo osteoide laminar, concreciones cemento-like o mezcla de ambos. La radiografía es la prueba de imagen de elección, y muestra una masa de densidad radiolúcida, radioopaca o mixta que no afecta al hueso subyacente. Puede existir erosión ósea superficial, focos centrales radioopacos, ensanchamiento del ligamento periodontal o desplazamientos dentarios1,5.
El diagnóstico diferencial se establece por correlación clínico-patológica con otras hiperplasias reactivas gingivales localizadas, como el granuloma piogénico, el fibroma gingival o el granuloma periférico de células gigantes, procesos benignos como displasia fibrosa u osteomielitis y con tumores óseos benignos (osteoma osteoide, osteoblastoma, cemento-blastoma) y malignos (osteosarcoma)1,4,6. En nuestra paciente se ha descartado el fibroma osificante juvenil, una variante del FCOP con peor pronóstico.
El tratamiento requiere escisión de la lesión y curetaje profundo de periostio y ligamento periodontal, con un 8-30% de recurrencias según las series2, en probable relación con curetaje insuficiente y con la persistencia de factores irritantes crónicos. No se ha descrito malignización4.
Los dermatólogos debemos conocer esta entidad con el fin de hacer un correcto diagnóstico diferencial y evitar pruebas y actuaciones innecesarias.
Conflicto de interesesLos autores declaran que no tienen ningún conflicto de intereses.